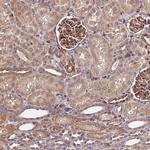
HERPUD1 Antibody in Immunohistochemistry (Paraffin) (IHC (P))

Search
Invitrogen
HERPUD1 Polyclonal Antibody
{{$productOrderCtrl.translations['antibody.pdp.commerceCard.promotion.promotions']}}
{{$productOrderCtrl.translations['antibody.pdp.commerceCard.promotion.viewpromo']}}
{{$productOrderCtrl.translations['antibody.pdp.commerceCard.promotion.promocode']}}: {{promo.promoCode}} {{promo.promoTitle}} {{promo.promoDescription}}. {{$productOrderCtrl.translations['antibody.pdp.commerceCard.promotion.learnmore']}}
产品信息
PA5-59282
种属反应
宿主/亚型
分类
类型
抗原
偶联物
形式
浓度
规格
纯化类型
保存液
内含物
保存条件
运输条件
RRID
产品详细信息
Immunogen sequence: RDLELSGDRG WSVGHLKAHL SRVYPERPRP EDQRLIYSGK LLLDHQCLRD LLPKQEKRHV LHLVCNVKSP SKMPEINAKV AESTEEPAGS NRGQYPEDSS SDGLRQREVL R
Highest antigen sequence identity to the following orthologs: Mouse - 86%, Rat - 84%.
靶标信息
The accumulation of unfolded proteins in the endoplasmic reticulum (ER) triggers the ER stress response. This response includes the inhibition of translation to prevent further accumulation of unfolded proteins, the increased expression of proteins involved in polypeptide folding, known as the unfolded protein response (UPR), and the destruction of misfolded proteins by the ER-associated protein degradation (ERAD) system. This gene may play a role in both UPR and ERAD. Its expression is induced by UPR and it has an ER stress response element in its promoter region while the encoded protein has an N-terminal ubiquitin-like domain which may interact with the ERAD system. This protein has been shown to interact with presenilin proteins and to increase the level of amyloid-beta protein following its overexpression. Alternative splicing of this gene produces multiple transcript variants, some encoding different isoforms. The full-length nature of all transcript variants has not been determined.
仅用于科研。不用于诊断过程。未经明确授权不得转售。
篇参考文献 (0)
生物信息学
蛋白别名: HERP; HERPUD1; homocysteine-inducible endoplasmic reticulum stress-inducible ubiquitin-like domain member 1 protein; homocysteine-inducible, endoplasmic reticulum stress-inducible, ubiquitin-like domain member 1; Homocysteine-responsive endoplasmic reticulum-resident ubiquitin-like domain member 1 protein; KIAA0025; Methyl methanesulfonate (MMF)-inducible fragment protein 1; MMS-inducible; unnamed protein product
基因别名: HERP; HERPUD1; KIAA0025; MIF1; SUP
UniProt ID: (Human) Q15011
Entrez Gene ID: (Human) 9709